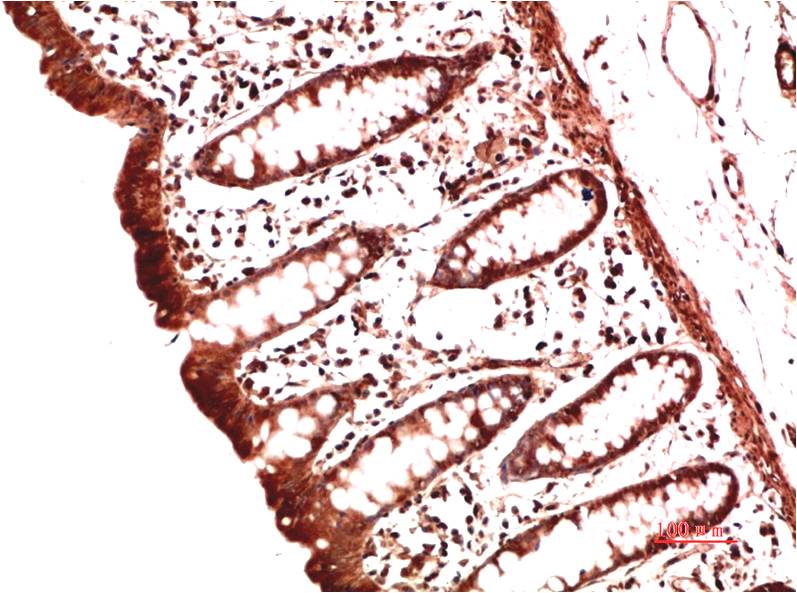

Collagen II Mouse Monoclonal Antibody(9F11)
Catalog NO.:BE3727
Applications :IHC
Reactivity :H,R,M
| 货号 | 规格 | 品牌 | 库存 | 价格 | 数量 | 操作 |
|---|---|---|---|---|---|---|
| BE3727-100 | 100ul | EASYBIO |
|

Collagens are fibrous, extracellular matrix proteins with high tensile strength and are the major components of connective tissue, such as tendons and cartilage. In cartilage, Collagen Type II constitutes the bulk of the fibril. Sensitization with Collagen Type II induces an erosive polyarthritis in rats, mice and higher primates which can resemble rheumatoid arthritis and relapsing polychrondritis.
| Product Name: | Collagen II Mouse Monoclonal Antibody(9F11) |
|---|---|
| Isotype: | IgG1 |
| Storage Buffer : | 1mg/ml in PBS, pH 7.4, containing 0.02% sodium azide and 50% glycerol |
| Storage instructions: | -20°C. Do not aliquot the antibody |
| Recommended dilutions: | IHC: 1:100-200 |
| Optimal dilutions should be determined by the end user. | |
| Specificity: | The Collagen I I Mouse Monoclonal Antibody can detects endogenous Collagen I I proteins. |
| Alternative Names: | Alpha 1 type I collagen, COL1A1, COL1A2 |
| Form: | Liquid |
| Reactivity: | H,R,M |
 暂无参考文献!
暂无参考文献!